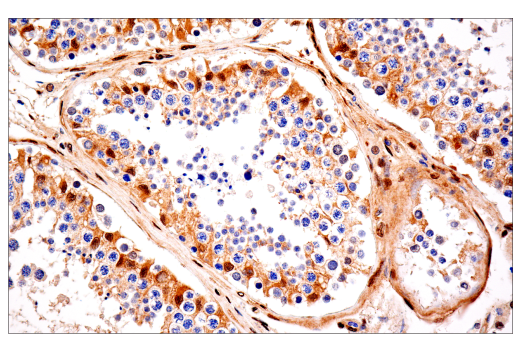

![【ぽよよん】 Y's BORN PRODUCT] COTTON TWILL CUT LINE KNEE PANTS(XS Mocha](https://static.mercdn.net/item/detail/orig/photos/m89254345614_1.jpg)
マイストア
変更
お店で受け取る
(送料無料)
配送する
納期目安:
2025.09.26 5:5頃のお届け予定です。
決済方法が、クレジット、代金引換の場合に限ります。その他の決済方法の場合はこちらをご確認ください。
※土・日・祝日の注文の場合や在庫状況によって、商品のお届けにお時間をいただく場合がございます。
【ぽよよん】 Y's BORN PRODUCT] COTTON TWILL CUT LINE KNEE PANTS(XS Mochaの詳細情報
Y's BORN PRODUCT] COTTON TWILL CUT LINE KNEE PANTS(XS Mocha。BUGOONY】STAR JAGUAR TEE|CONVERSE TOKYO (コンバース。YAP/TAZ (E9M8G) Rabbit mAb (BSA and Azide Free) | Cell。BUGOONY】STAR JAGUAR TEE|CONVERSE TOKYO (コンバース。・バックプレート1500円・4ボタン設置(パターン②、静音ボタン)6000円・beaver tail(ブラック)1000円・edgeスティック2500円・引取時お支払い分300円・返送時送料750円
ベストセラーランキングです
近くの売り場の商品
カスタマーレビュー
オススメ度 4.4点
現在、3454件のレビューが投稿されています。
![【ぽよよん】 Y's BORN PRODUCT] COTTON TWILL CUT LINE KNEE PANTS(XS Mocha](https://media.cellsignal.com/cdn-cgi/imagedelivery/JWox9JU8xLM9DWO4l_Iqsw/2b642cfe-0f08-4bb4-b678-e6cc1268d100/public)
![【ぽよよん】 Y's BORN PRODUCT] COTTON TWILL CUT LINE KNEE PANTS(XS Mocha](https://media.cellsignal.com/cdn-cgi/imagedelivery/JWox9JU8xLM9DWO4l_Iqsw/534e7f44-13d4-4798-bb5a-208e434d2600/public)
![【ぽよよん】 Y's BORN PRODUCT] COTTON TWILL CUT LINE KNEE PANTS(XS Mocha](https://converse-tokyo.jp/photo/2022/A2859UTS009/zz-A2859UTS009-1.jpg)
![【ぽよよん】 Y's BORN PRODUCT] COTTON TWILL CUT LINE KNEE PANTS(XS Mocha](https://converse-tokyo.jp/photo/2020/A2808PAC406/zz-A2808PAC406-7.jpg)




![Y's BORN PRODUCT] COTTON TWILL CUT LINE KNEE PANTS(XS Mocha Y's BORN PRODUCT] COTTON TWILL CUT LINE KNEE PANTS(XS Mocha](https://theshopyohjiyamamoto.jp/img/goods/YB-P80-002/YB-P80-002_1-8.jpg)